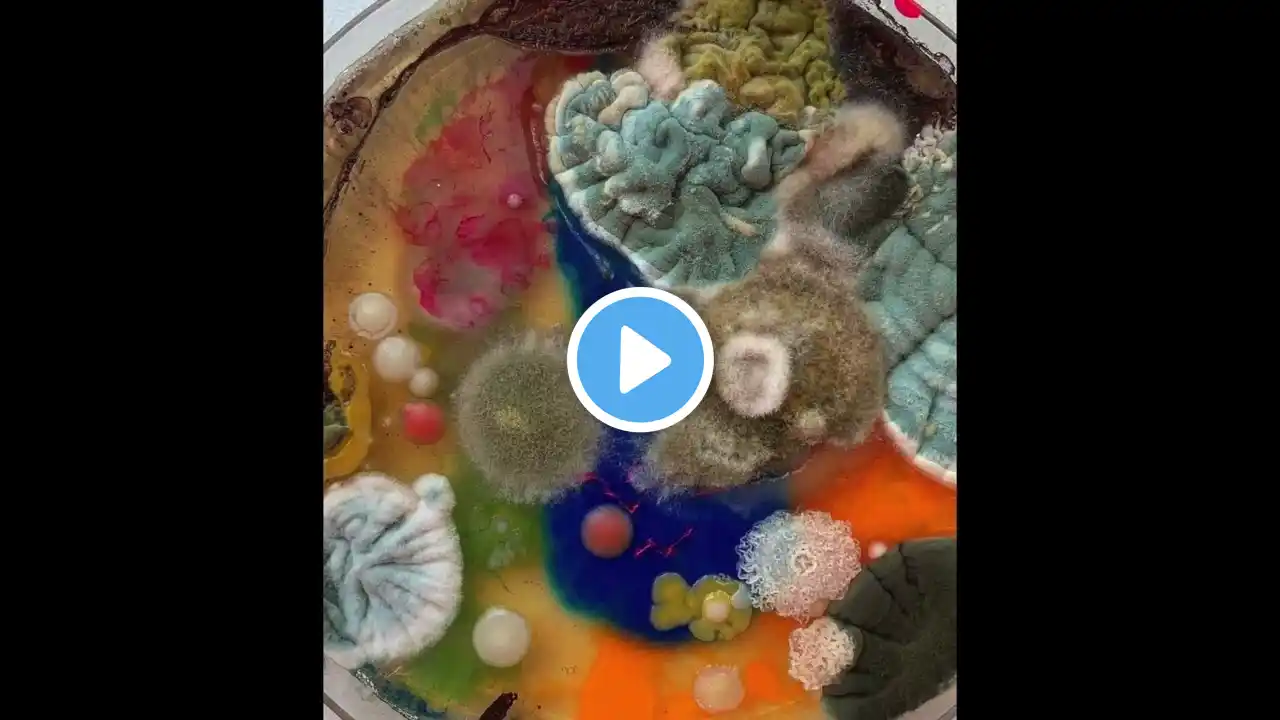
ภาพตัวอย่างวิดีโอ

![[FREE] A$AP ROCKY X CLAMS CASINO TYPE BEAT | (prod. cam)](https://thaitubemp3.com/image/lbVkPoTVhe4.webp)
[FREE] A$AP ROCKY X CLAMS CASINO TYPE BEAT | (prod. cam)
Leave a Like 💖 📸 : www.instagram.com/cameron.eberhardt Email: [email protected] IMPORTANT THIS BEAT IS FOR PROFIT USE ON YOUTUBE/SOUNDCLOUD TO USE ON STREAMING SERVICES (ie apple music/spotify) REQUIRES LICENSE (dm on ig best way) MUST CREDIT (prod. cam) ------------------------------------------------------------------------------ (ignore) drake type beat,drake type beat 2021,drake type beat free,free drake type beat,free drake type beat 2021,drake certified lover boy type beat,drake sample type beat,drake sample type beat 2021,free drake sample type beat,free drake sample type beat 2021,drake x partynextdoor type beat 2021,drake type instrumental,drake type instrumental 2021,drake instrumental,drake intro type beat,drake outro type beat 2021,drake leak,drake clb type beat,clb type beat drake,free beats,type beat 2021,jack harlow type beat,dark lane demo tapes type beat,playboi carti type beat,drake dark lane demo tapes type beat,drake type beat 2021,type beat,pop type beat,lil durk type beat,pierre bourne type beat,cedes,jack harlow type beat 2021,certified lover boy type beat,drake sample type beat,partynextdoor type beat,drake certified lover boy,drake certified lover boy type beat,lil durk type beat 2020,tory lanez type beat,free type beat,skeyez beats,melodic type beat,free drake type beat 2021,laugh now cry later type beat,sample type beat,free type beat 2021,wheezy type beat,travis scott type beat 2020,drake sampled type beat,free melodic type beat,6lack type beat,free sample type beat,cedes type beat,popstar type beat,type beat melodic,pop type beat 2021,travis scott type beat,drake x tory lanez type beat,rnb trap type beat,bryson tiller type beat,drake type beats,rnb type beat,free type beats,type beats,trap type beat 2021,bryson tiller type beat 2020,beats 2021,type beat free,drake type beat free,pop beat,drake hard type beat,type beat 2020,bryson tiller type beat free,free drake type beat 2020,free trapsoul type beat,type beat drake,free drake type beat,free bryson tiller type beat,freestyle type beat,hard type beat,drake type beat hard,free sad type beat,trap type beat,wheezy type beat 2021,type beat rnb,free beat,drake certified lover boy type beat free,drake certified lover boy type beat 2021,sample type beat 2021,type beat 2020 free,drake sample type beat 2021,free beats,melodic type beat 2021,hard trap beat,drake x tory lanez type beat 2021,freestyle beat,drake,type beat sad,drake x travis scott type beat,rap beat,drake x pierre bourne type beat,instrumental,drake wheezy type beat,drake type instrumental,pierre bourne type beat 2021,noah 40 shebib type beat,beats,drake x playboi carti type beat,free drake hard type beat 2021,trap instrumental,drake clb type beat,drake boi 1da type beat 2020,freestyle beats,hard trap beats,drake laugh now cry later type beat,free beats to use,beat,drake trippie redd type beat,drake x noah 40 type beat,free beats 2021,free drake x pierre bourne type beat,certified loverboy type beat,free drake beats 2021,drake playboi carti type beat,instrumental rap,rap instrumental,free type beat drake,free instrumental,drake laugh now cry later,playboi carti x drake x pierre bourne type beat,drake beats 2021,partynextdoor type beat 2020,free trap type beat,drake interlude type beat,drake beat,drake beats,instrumental hip hop,cedes drake type beat,drake instrumental,trap rap beat,outro drake type beat,drake emotional type beat,certified lover boy,dark r&b type beat,free drake sample type beat,drake lil durk type beat,drake hard type beat 2021,hard trap type beats,instrumental free,the boy,drake soulful type beat,rnb type beat 2021,lil durk drake type beat,drake type beat free 2020,instrumentals,drake type instrumental 2021,drake instrumentals,free beat instrumental,free beats instrumental,rap instrumental beat,laugh now cry later instrumental,drake soul type beat,drake instrumental beats,hard type beat 2021,hard type beat instrumental,2021 instrumental,free drake hard type beat,drake type instrumentals,hard drake type beats,drake type beats free,drake insturmental,free drake beat,hot type beat,drake instrumental type beat,drake free instrumental,drake lil durk instrumental,prod the boy,drake dark lanes,drake new,certified lover boy type beat drake,noah 40 shebib type beat 2021